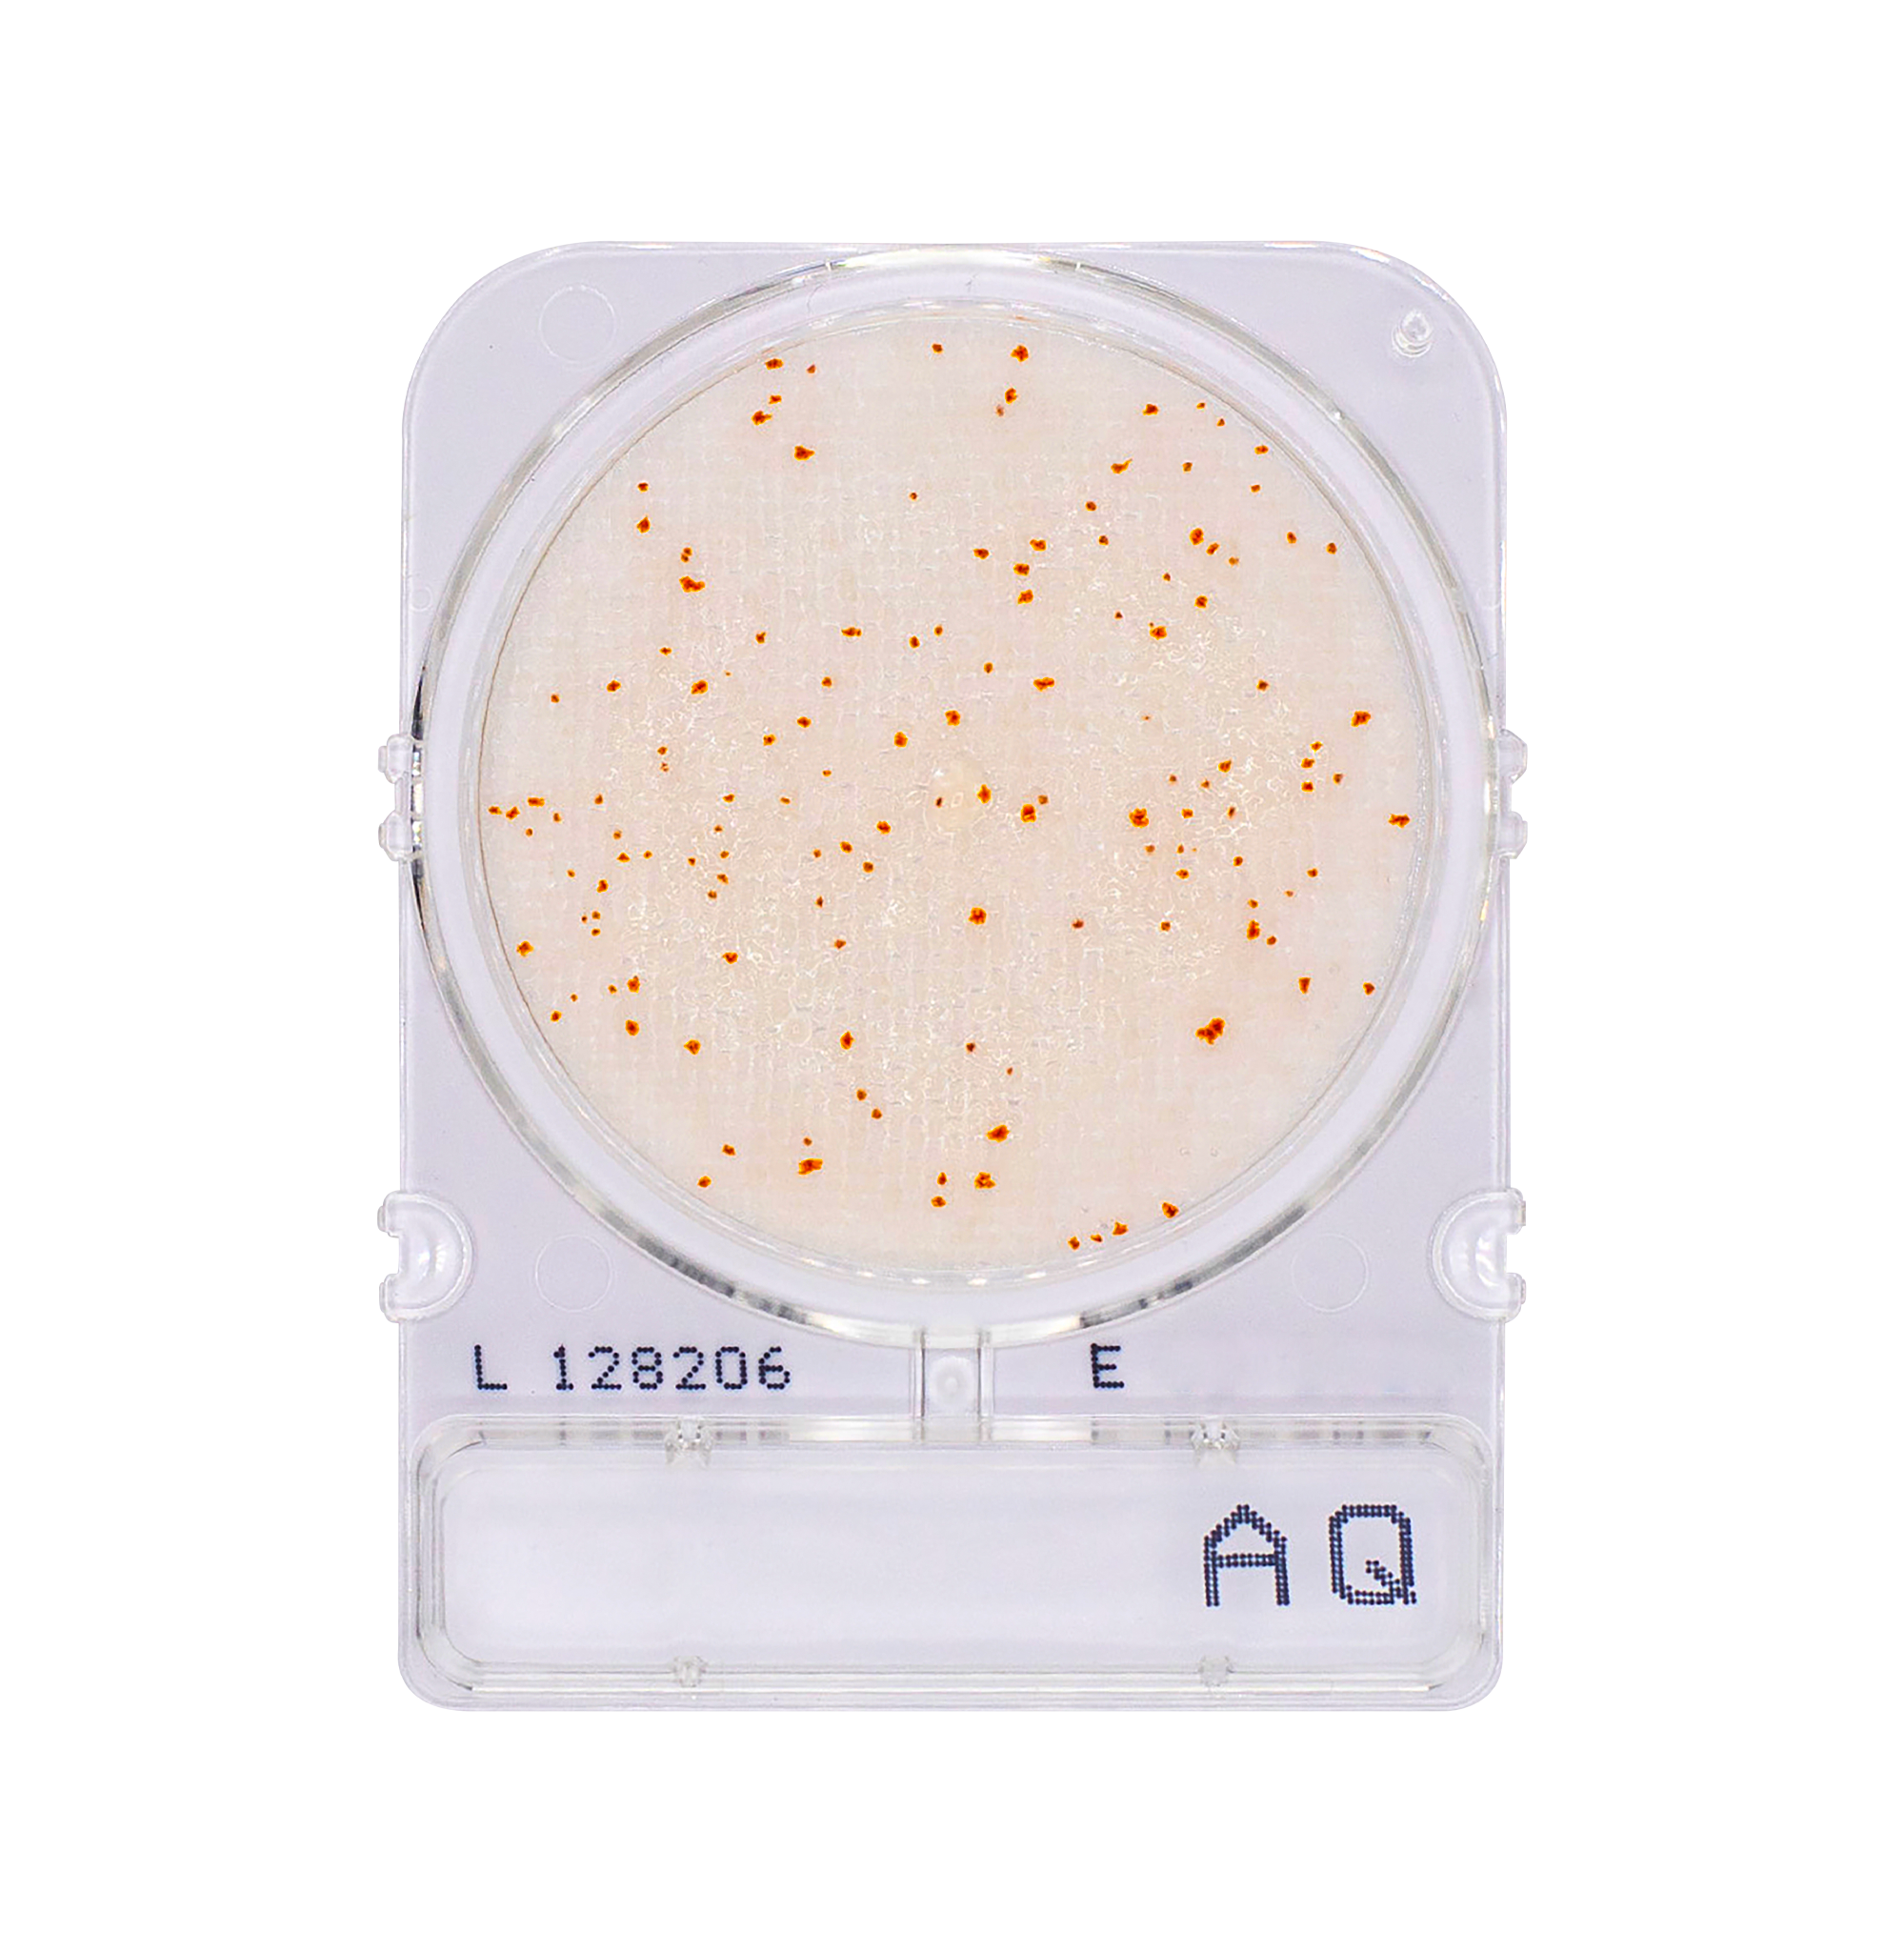
Compact Dry AQ | Heterotrophic Bacteria
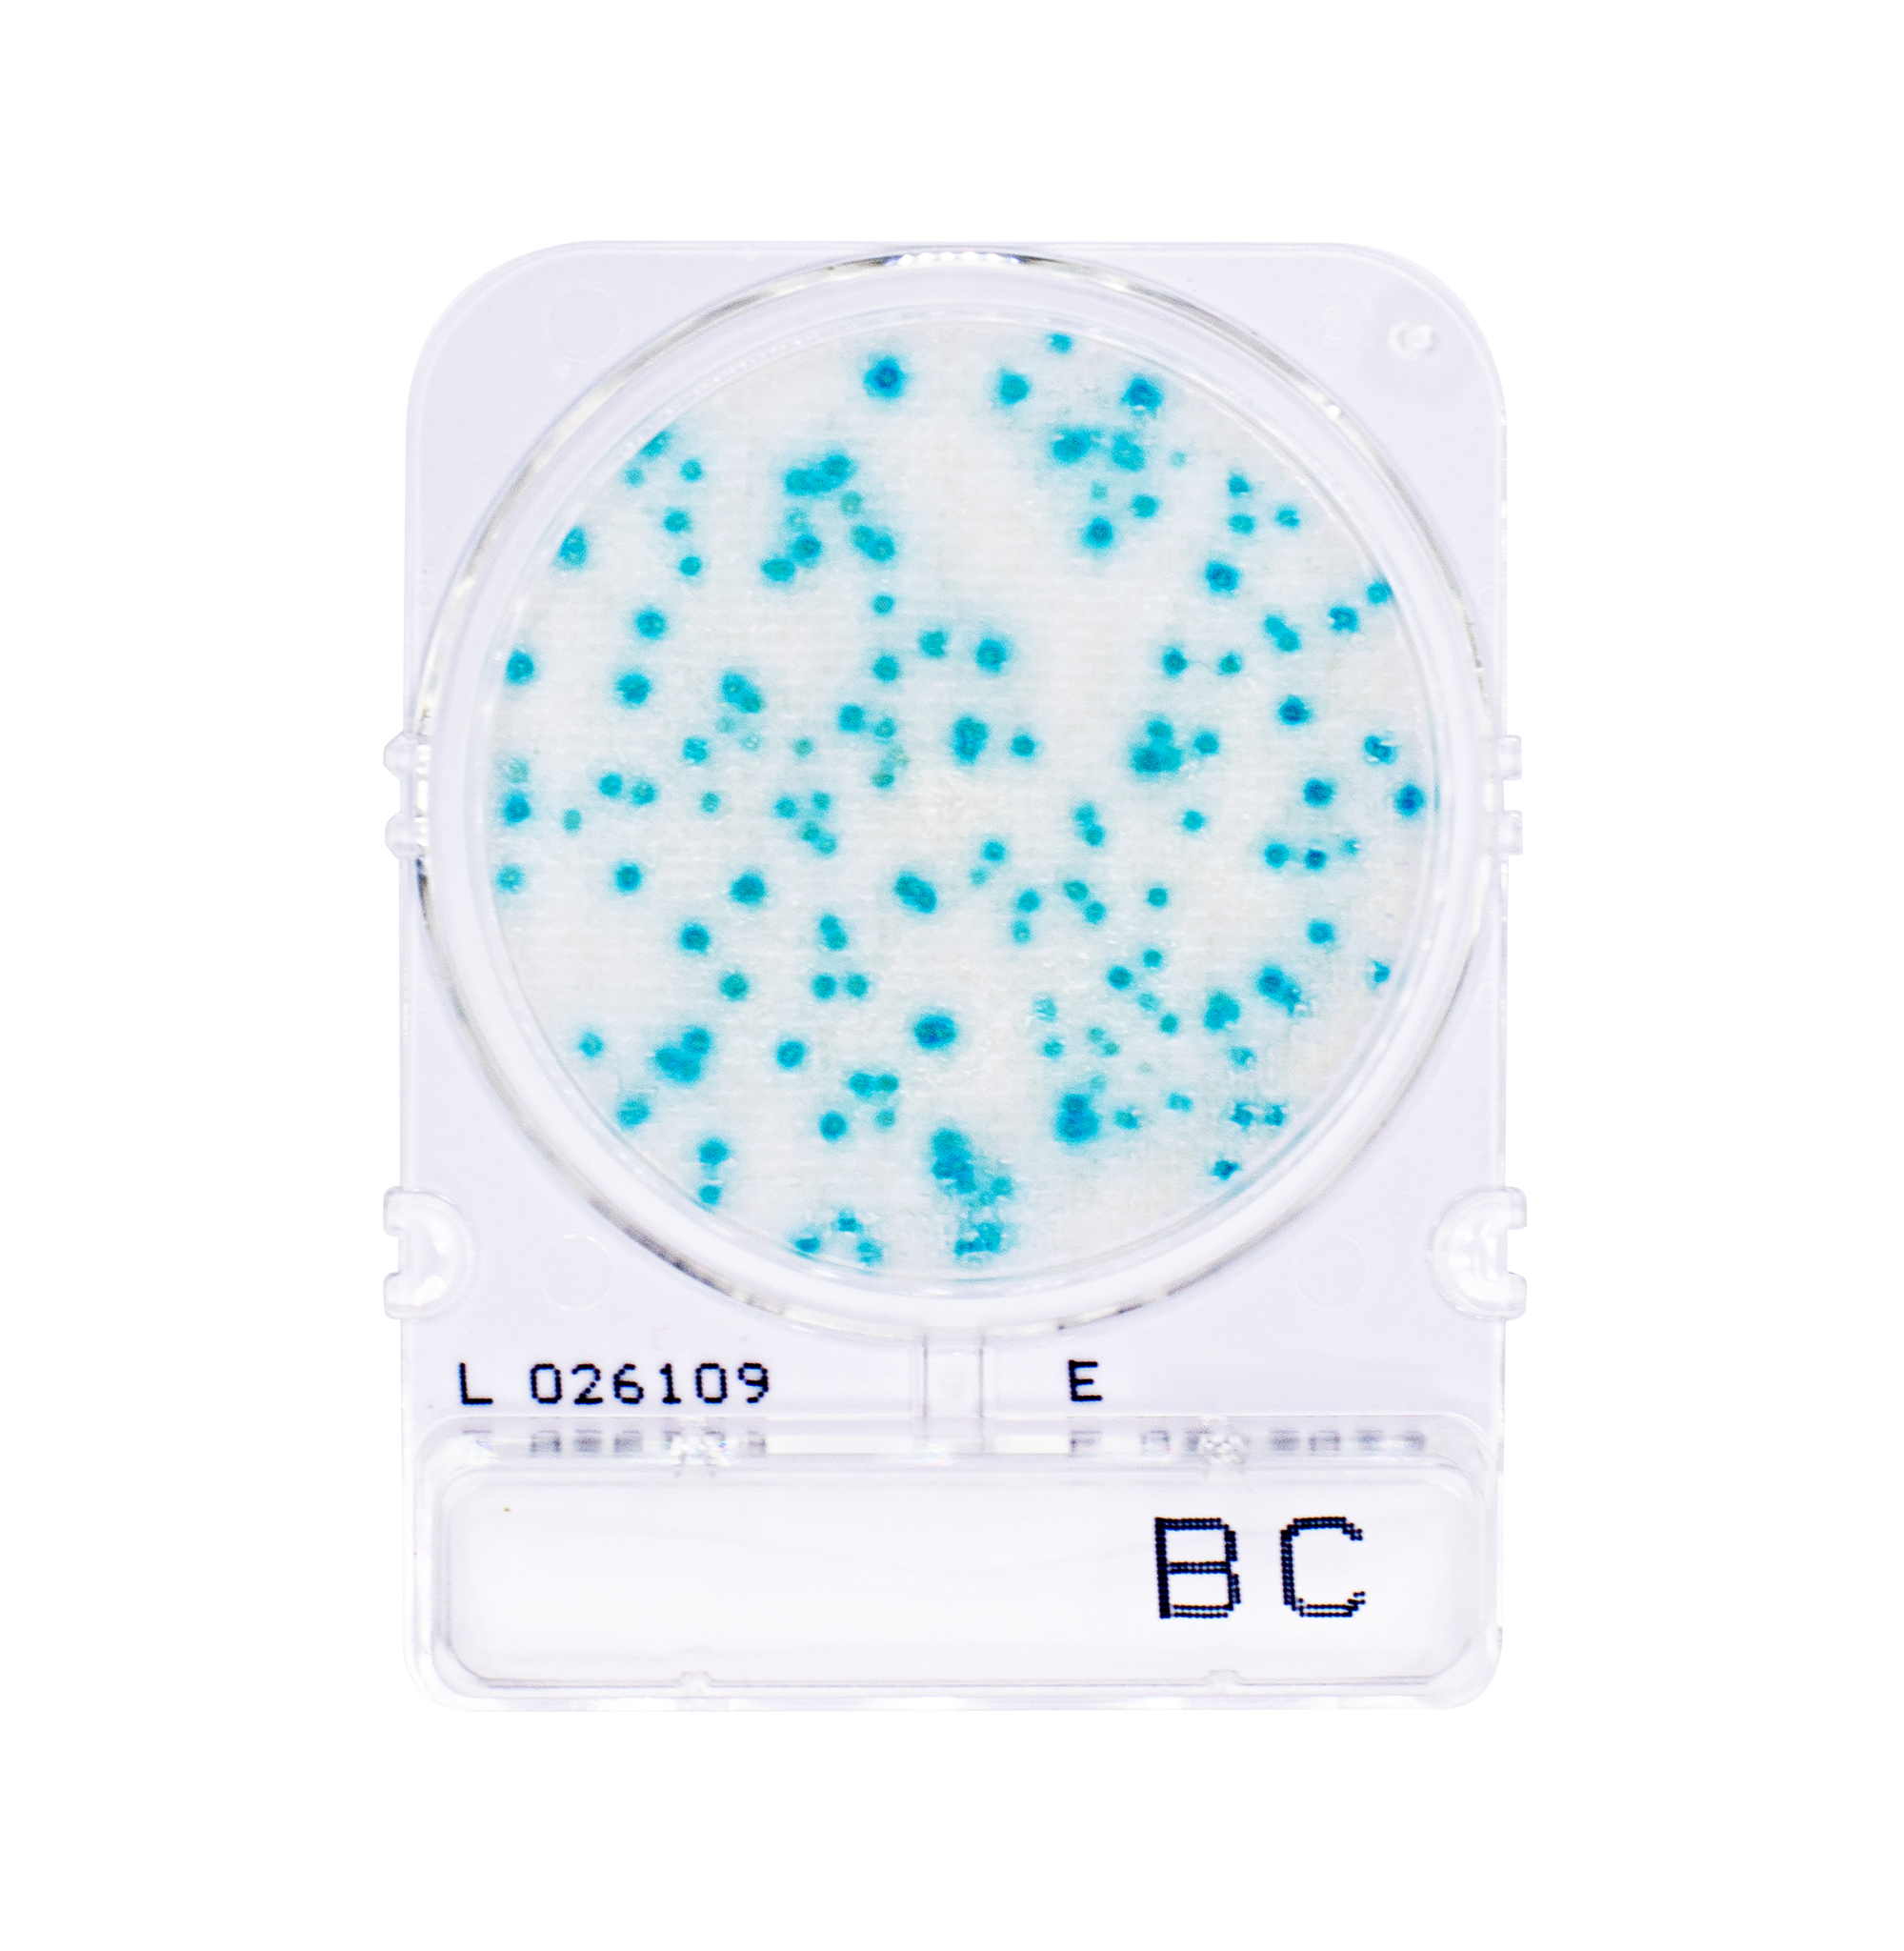
Compact Dry BC | Bacillus cereus
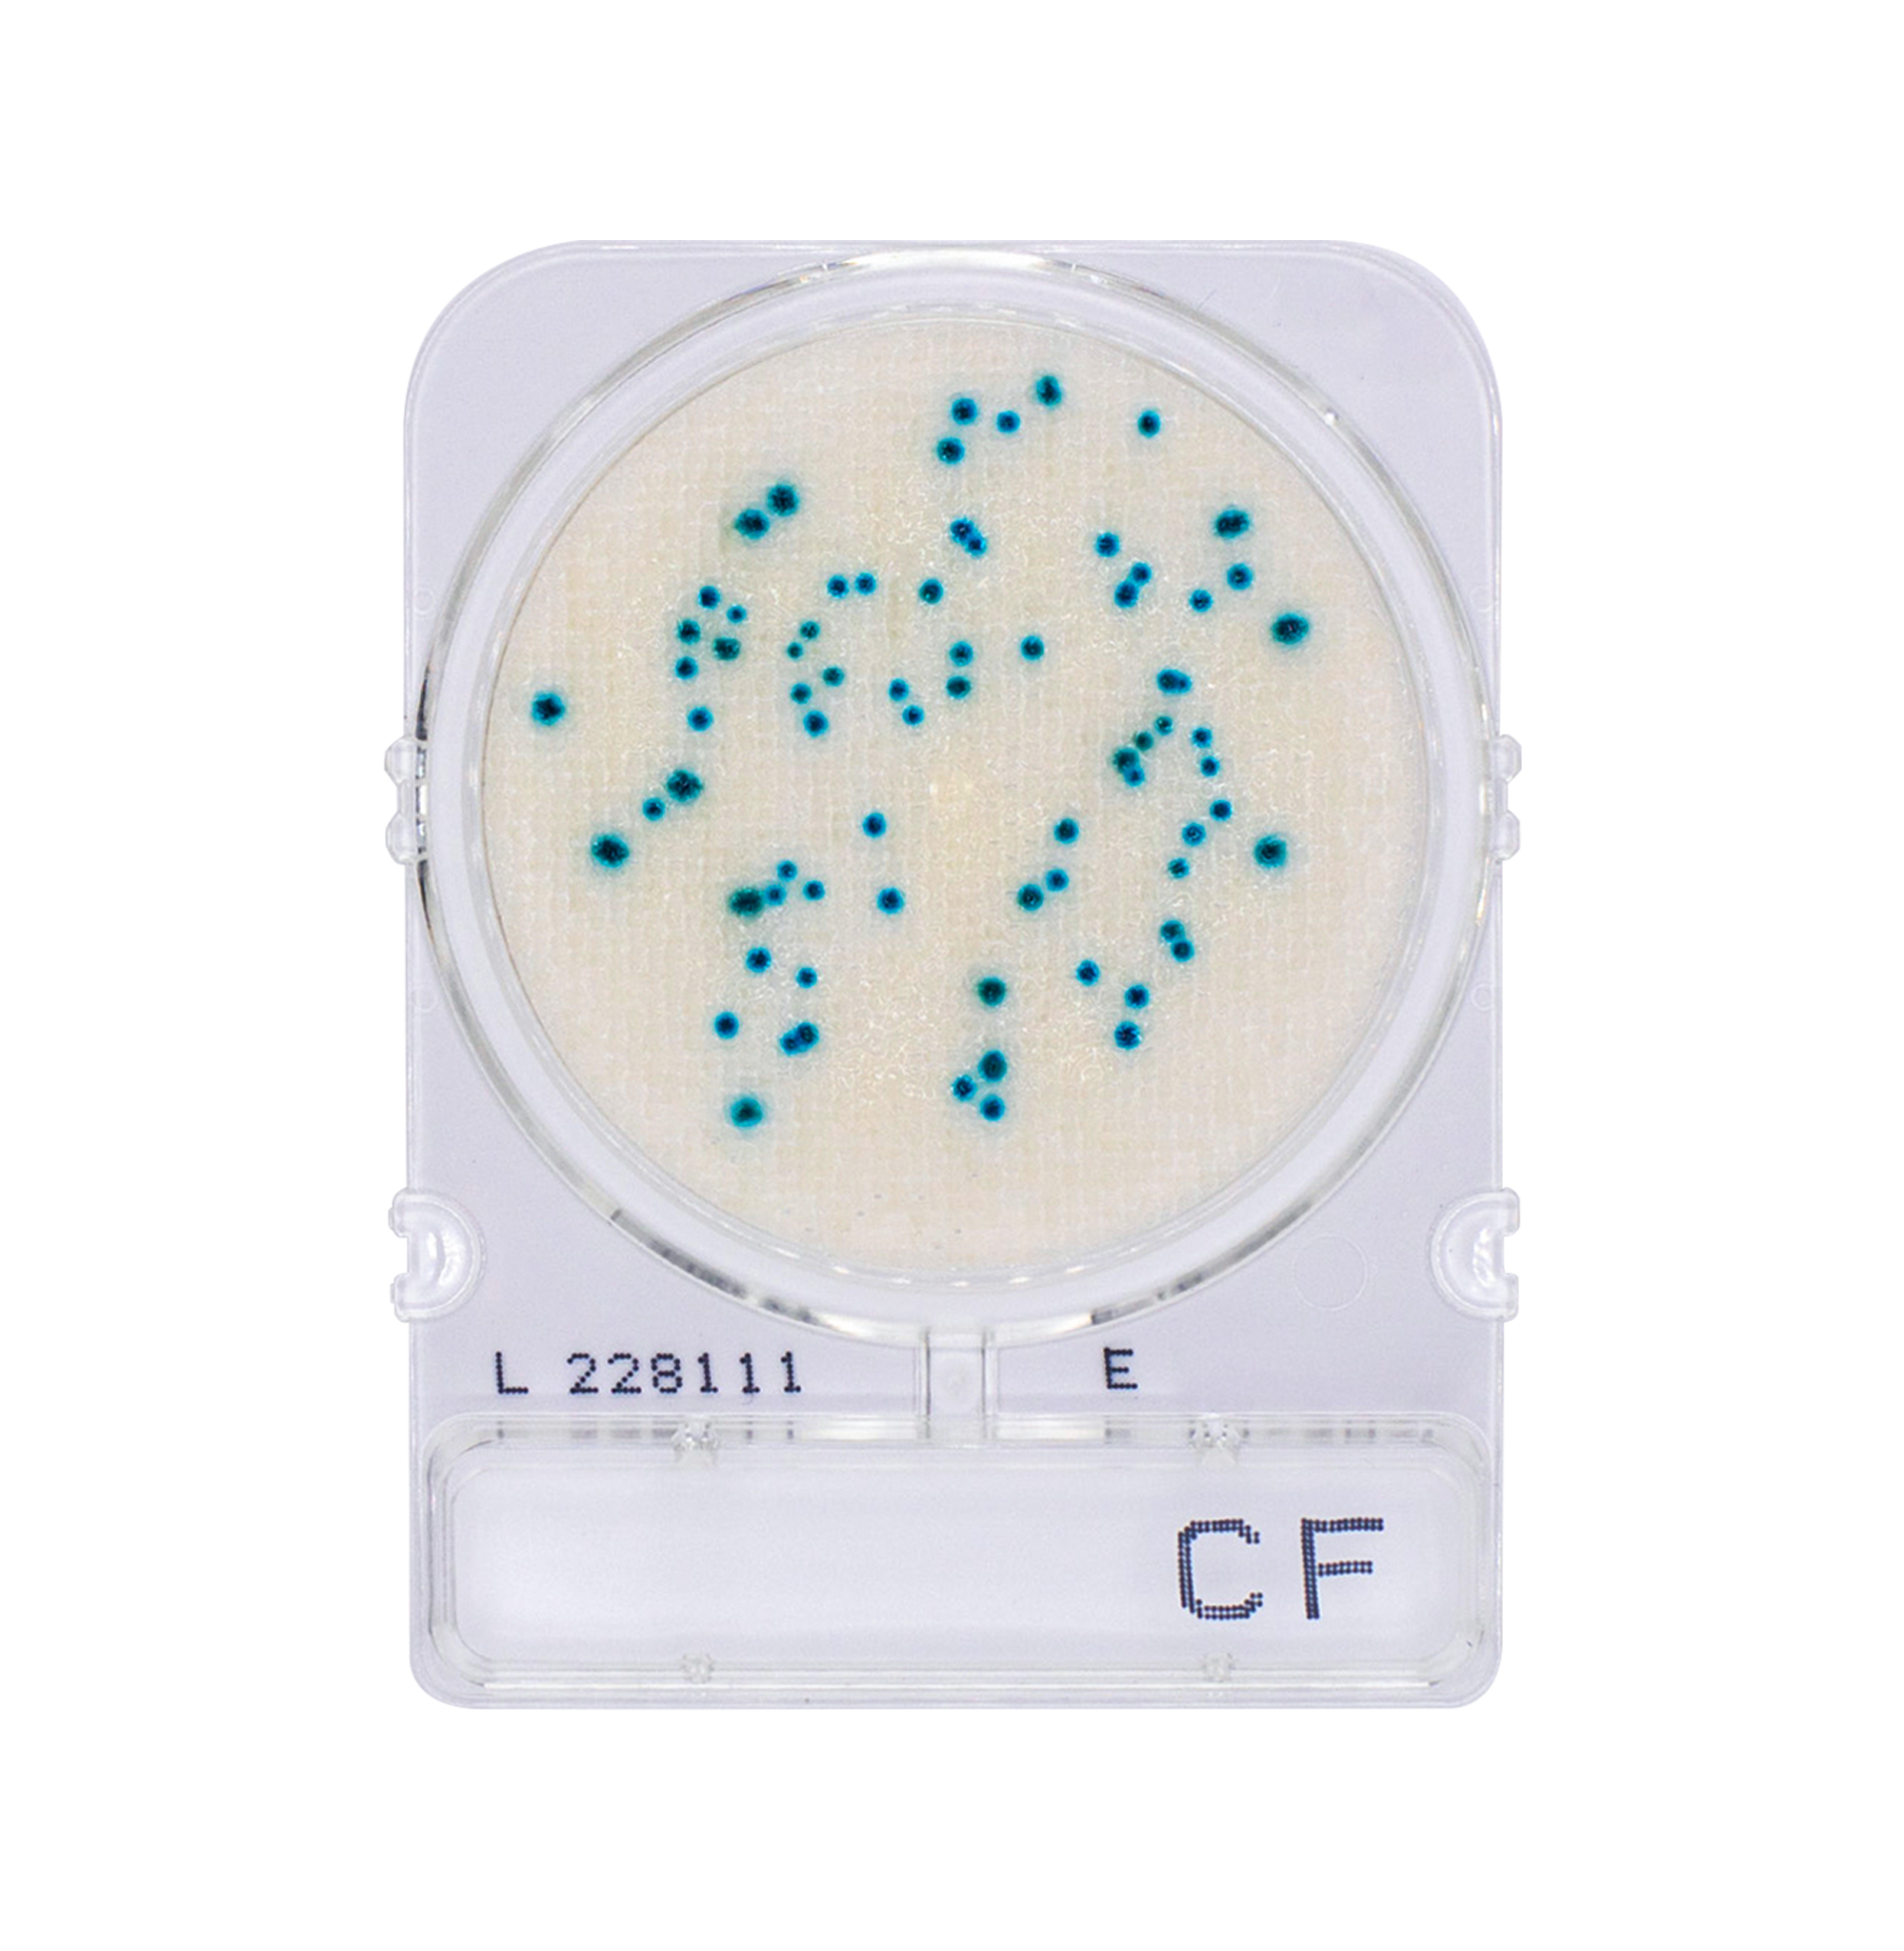
Compact Dry CF | Coliform
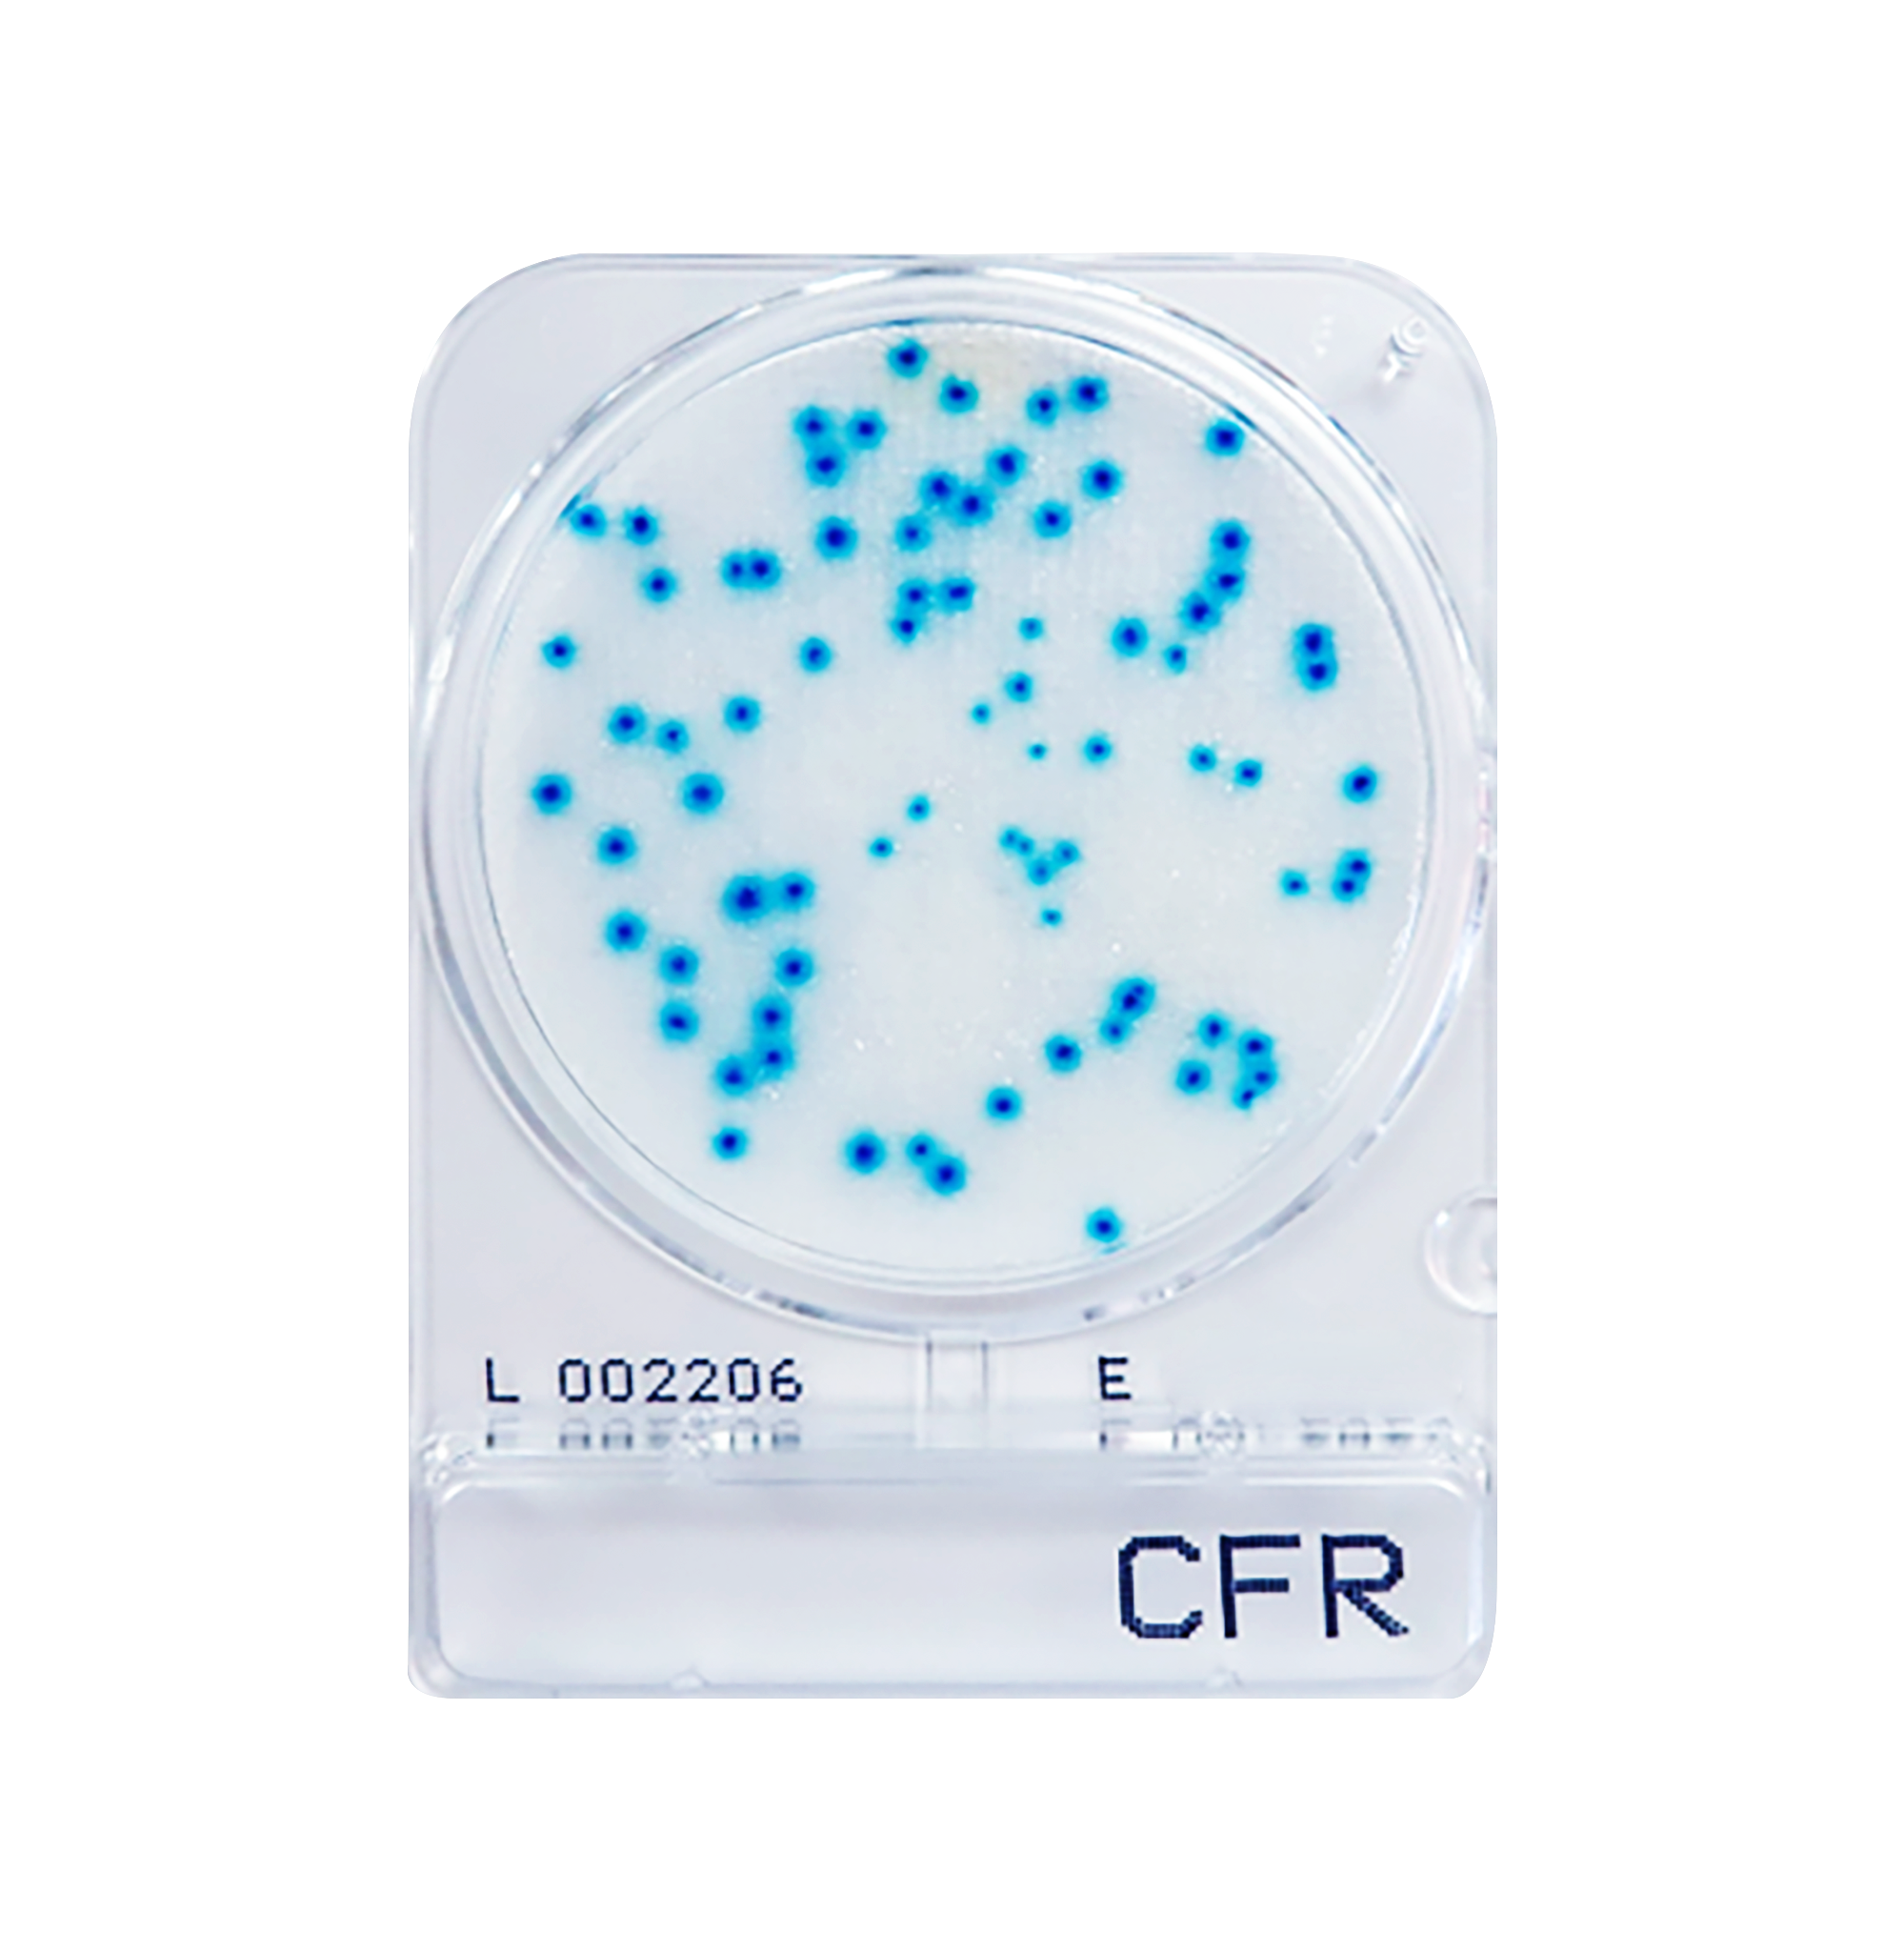
Compact Dry CFR | Coliform - Rapid
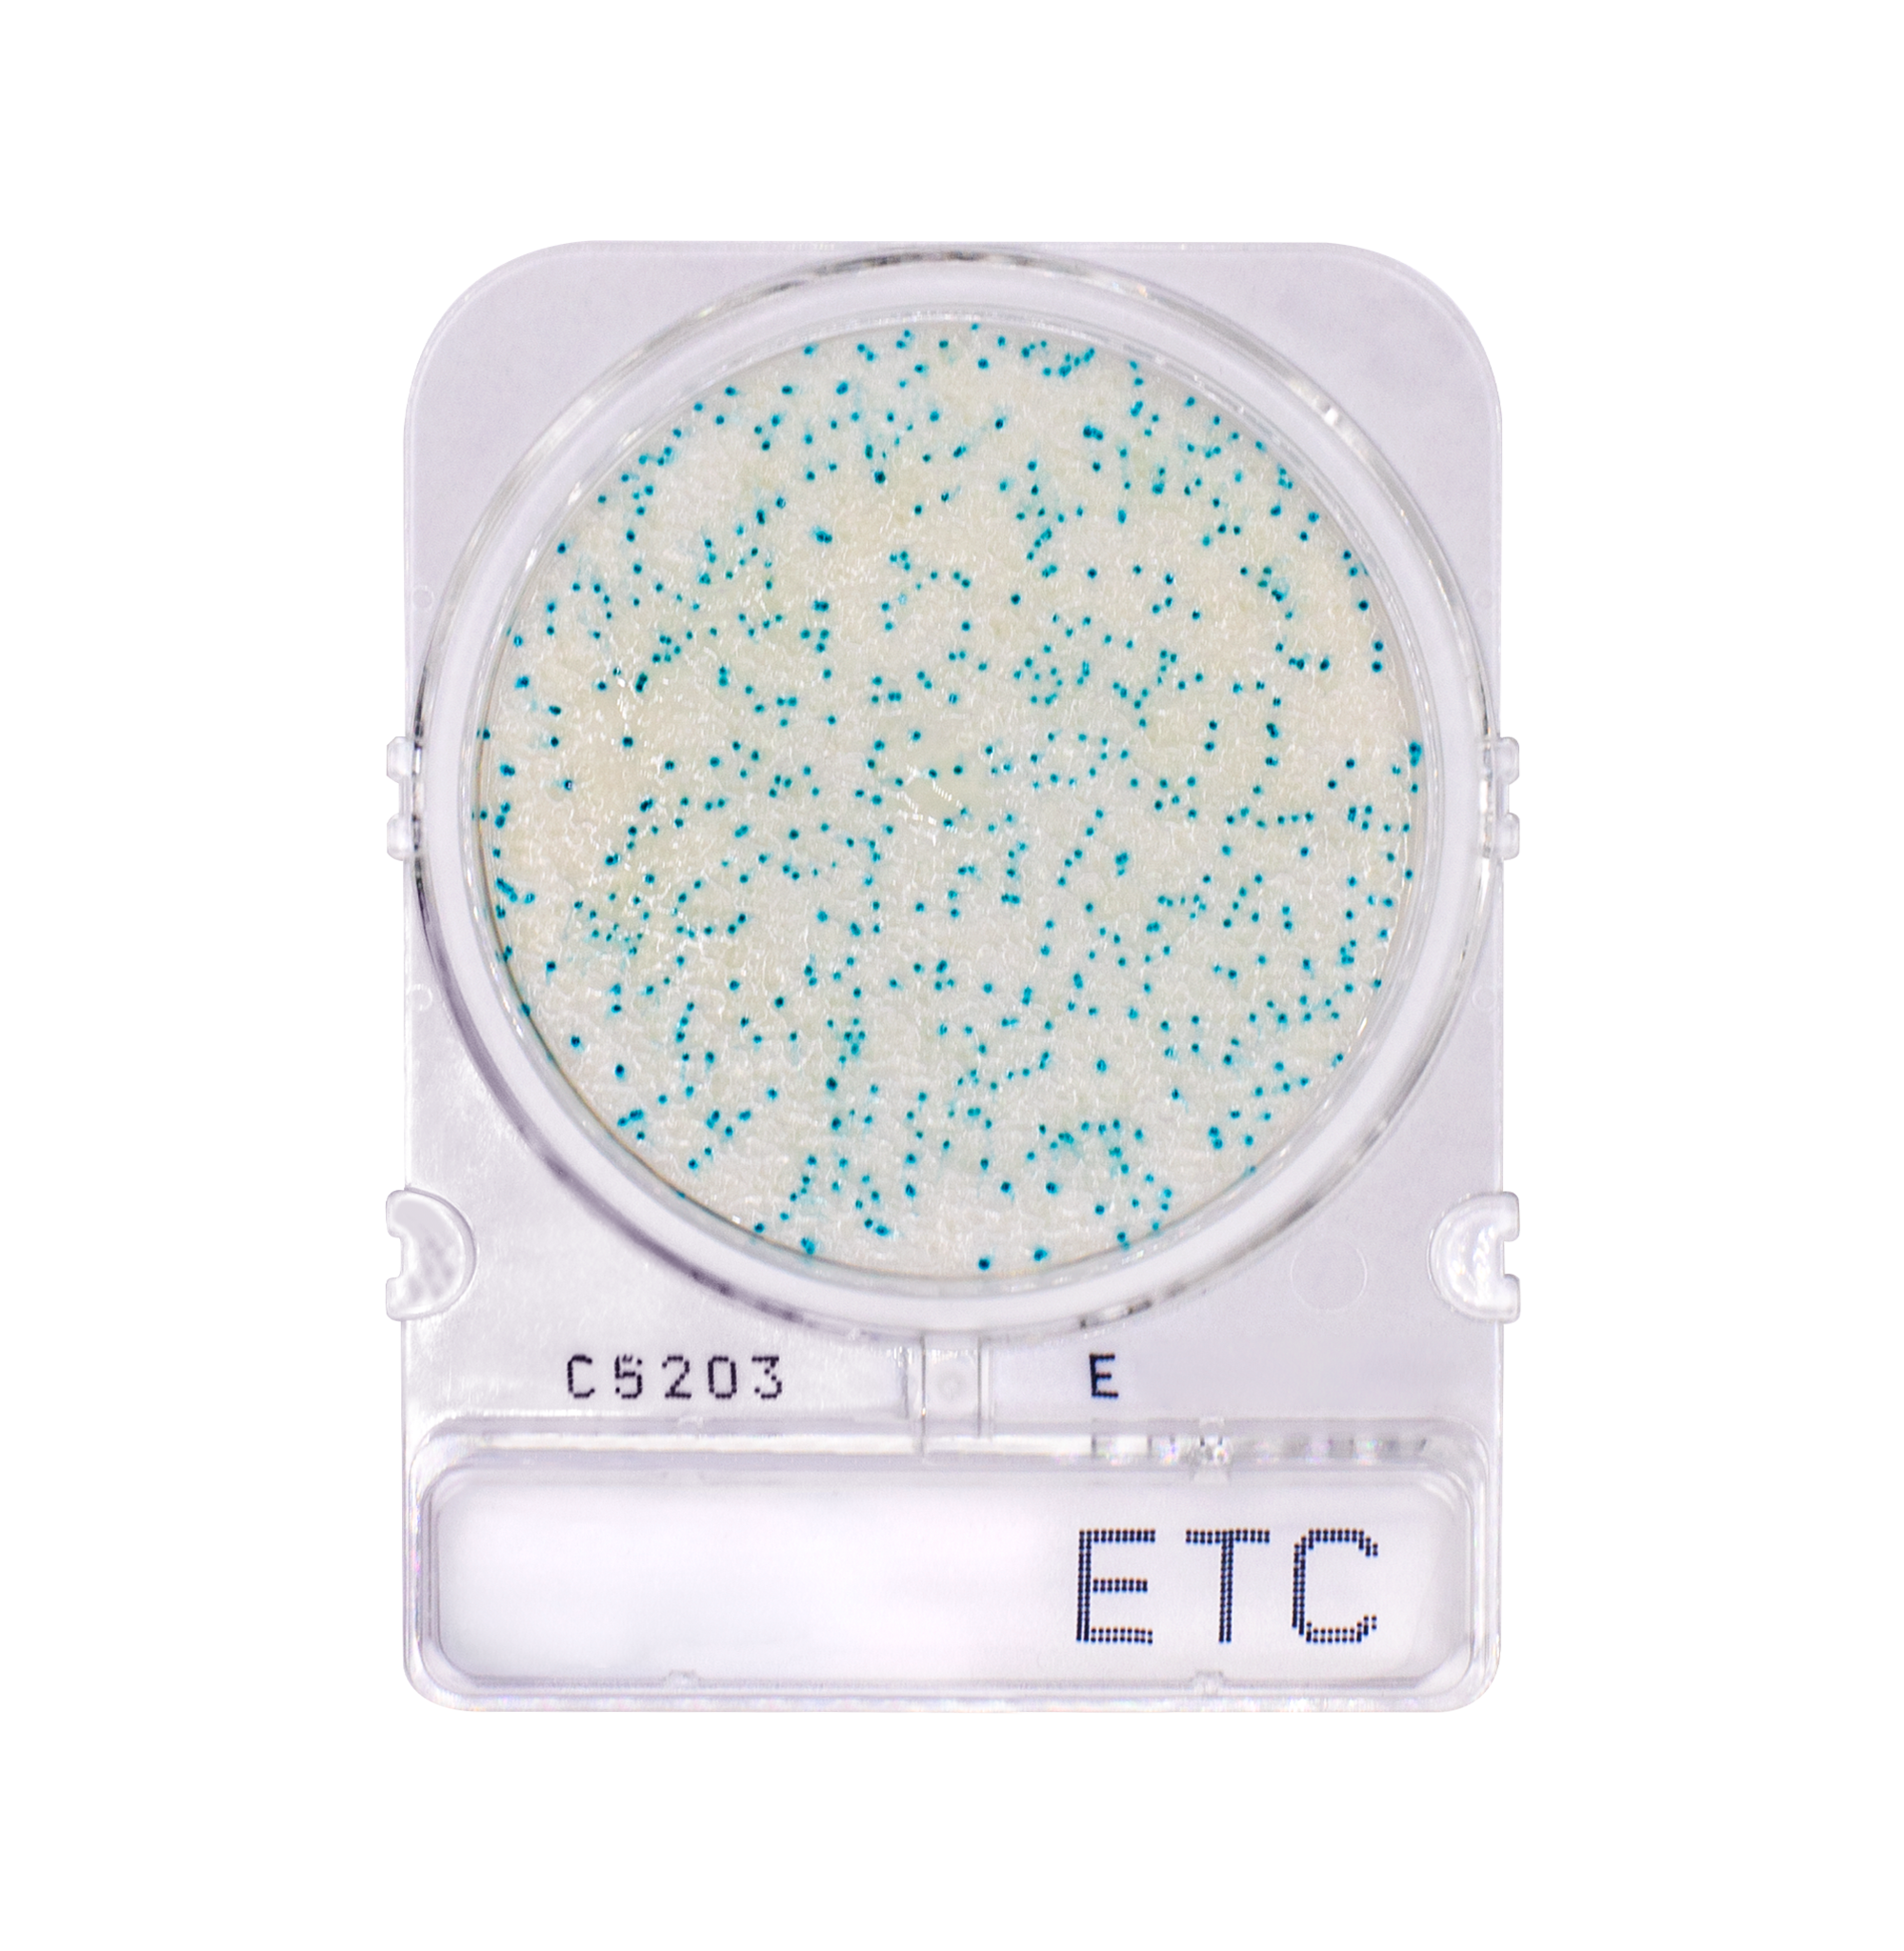
Compact Dry ETC | Enterococci
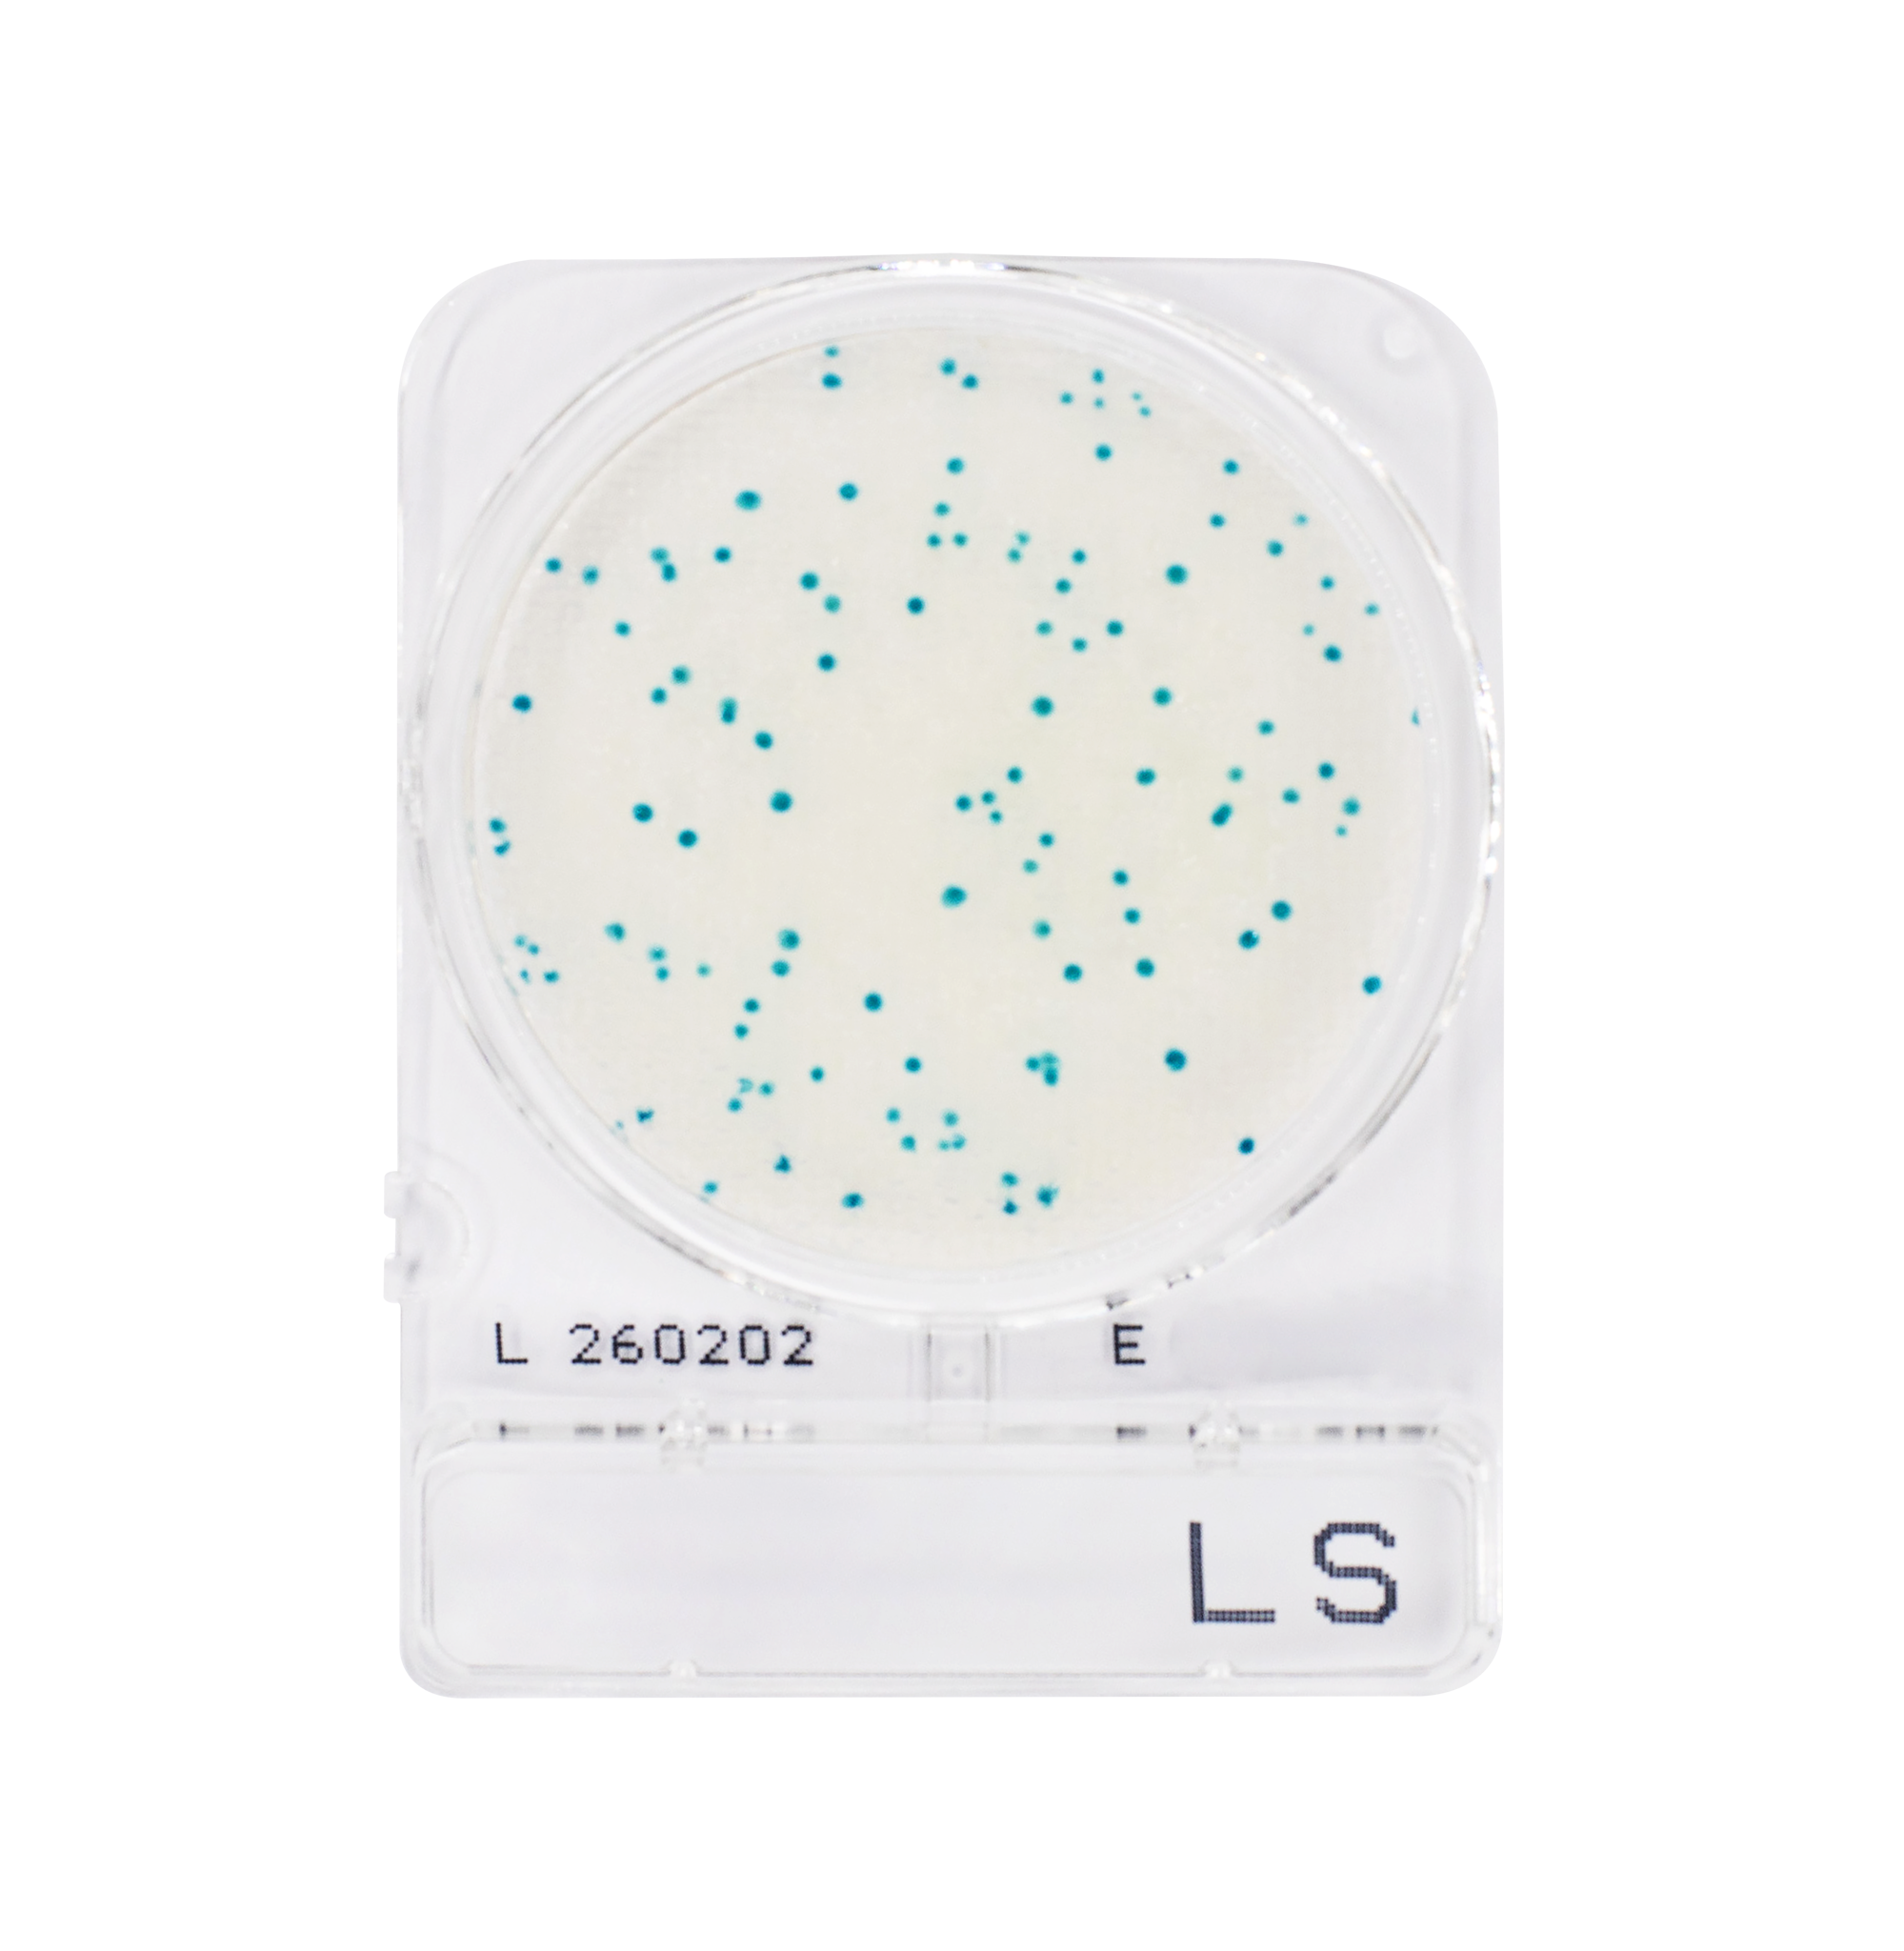
Compact Dry LS | Listeria spp
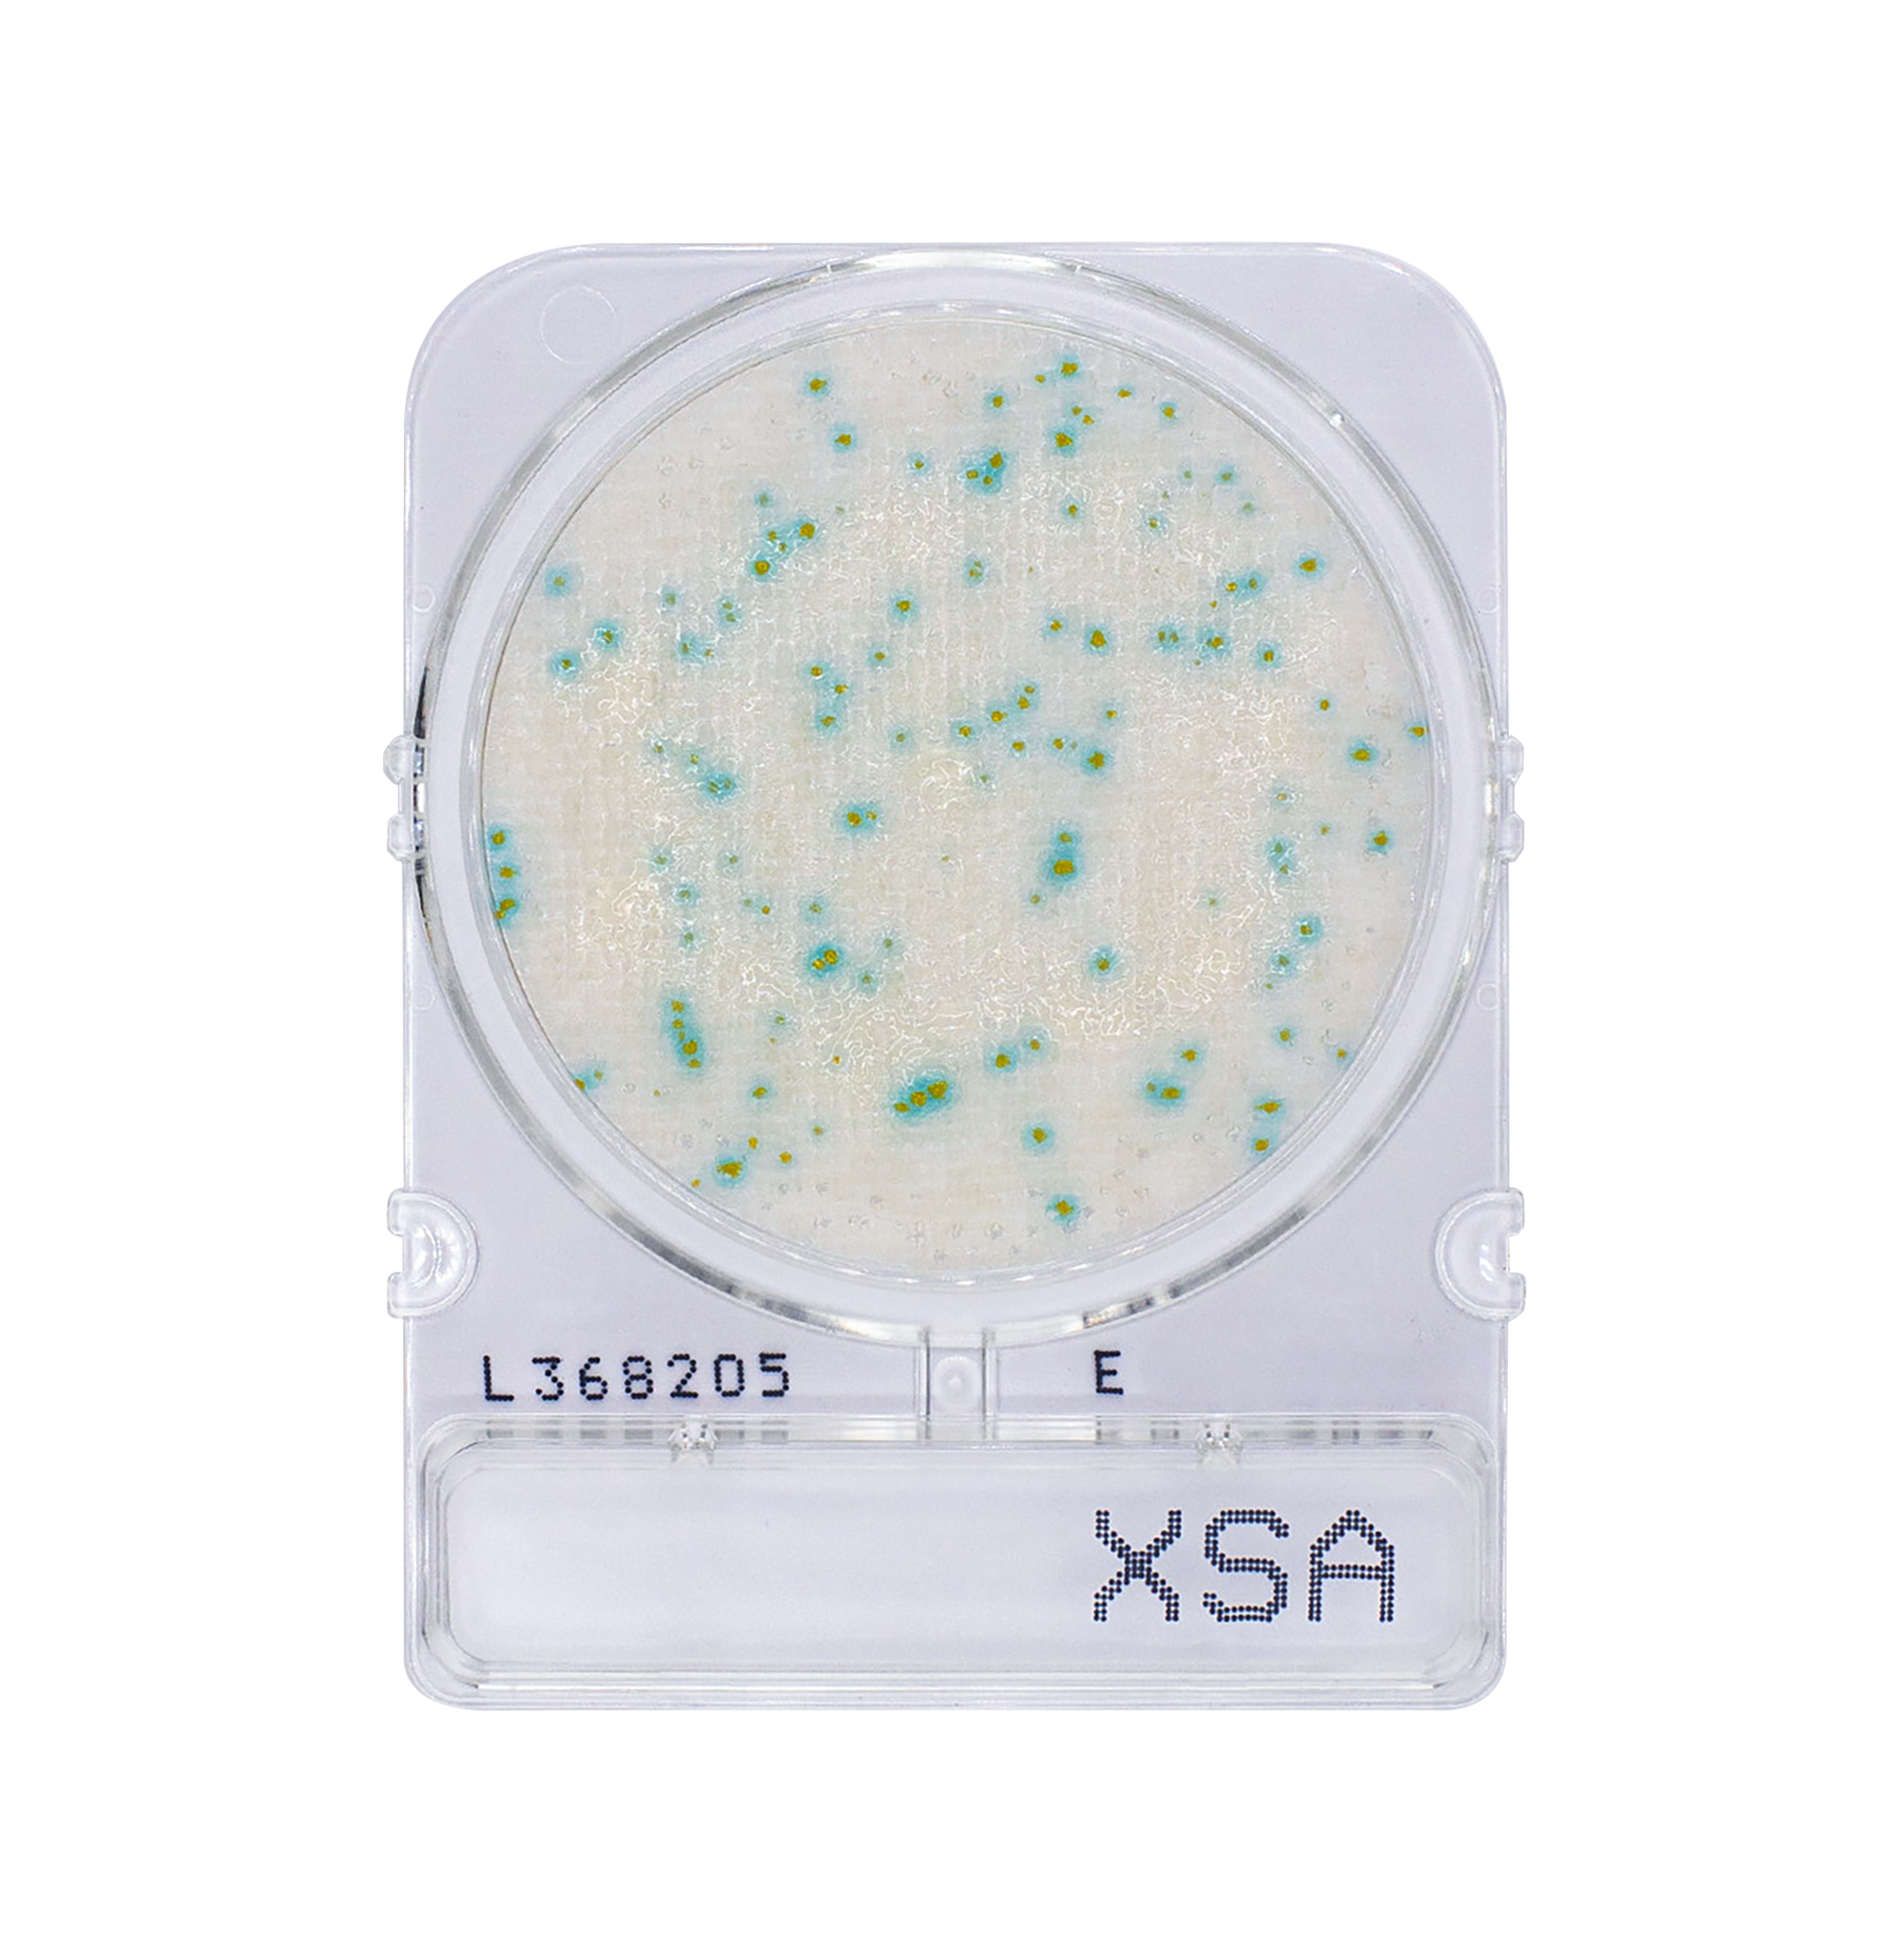
Compact Dry X-SA | Staphylococcus aureus

Simple. Safe. Efficient.
Detect and quantify microorganisms in raw materials, in-process samples, finished products, and environmental samples. Each plate is pre-prepared, self-diffusing, rigid, and stackable, and can be stored at room temperature, helping laboratories save time, space, and cold storage capacity.
Whether testing food, water, cosmetics, or pharmaceuticals, Compact Dry offers consistent performance and convenience in one compact format.
Next, add a background image
Rigid frame with aerobic headspace
No need for spreader
Stack up to 60 plates
Room temperature storage
Easily select intact colony for confirmation
Explore Compact Dry Products

Pair with Compact Vision
Revolutionize your lab workflow with our expertly designed AI plate reader for Compact Dry Plates.
Surface Sampling
Air Sampling
Water Sampling